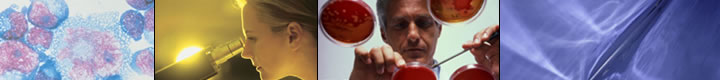
image

Welcome to Mycropaths Technologies...
A Laboratory investigating microbial pathogenesis
Welcome to the homepage of MYcropaths Technologies. It is our hope that this site effectively communicates the areas of research we have undertaken concerning microbial pathogenesis. Hopefully, all visitors to this site will find something of interest in the following pages. In the event you are unable to find what you need please check back at a later time because this site will be continuously updated as we discover more concerning the pathogenesis of the endemic microbial pathogens.
Academic Research
Mycropaths Technologies research specialties are disease pathogenesis and diagnostic design, particularly the pathogenesis and diagnostics of infectious diseases.
This work covers the pathogenesis of Histoplasma capsulatum and Blastomyces dermatitidis. These endemic fungal pathogens are responsible for histoplasmosis and blastomycosis, affecting individuals with compromised or suppressed immune systems, such as the aged, individuals with AIDS, and cancer and transplant patients.
Recent research includes the pathogenesis and diagnostics of Alzheimer's disease and diabetes. Initial experiments are increasing our understanding of the significance of post-translational protein modification to Alzheimer’s pathogenesis and fat distribution and metabolism involved in the pathogenesis of both of these diseases.
Consulting: Laboratory Design, Construction and Administration
Let us help you solve your research problems more efficiently and trouble-free. Mycropaths consulting services cover the following areas:
- Includes academic and industrial research facilities
- Lab design and construction
- Equipment requirements and installation
- Maintenance requirements
- Experiment design and implementation
- Professional consultation to plan, build and run an efficient laboratory facility
View Site Map
|